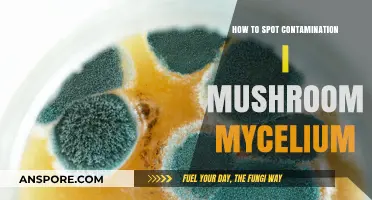
Identifying Contamination in Mushroom Mycelium: Essential Tips for Healthy Growth

The death cap mushroom, scientifically known as *Amanita phalloides*, is one of the most poisonous fungi in the world, responsible for numerous fatalities due to its resemblance to edible mushrooms. Identifying this deadly species is crucial for foragers and nature enthusiasts, as it often grows in wooded areas, particularly under oak, beech, and pine trees. Key features to look for include a pale green to yellowish cap, typically 5–15 cm in diameter, with a smooth, sticky surface and a distinct volva (cup-like structure) at the base of the stem. The gills are white, and the stem is usually pale with a skirt-like ring. However, relying solely on visual characteristics can be risky, as variations in appearance exist, and some edible mushrooms share similar traits. Always consult a field guide or expert, and avoid consuming wild mushrooms unless absolutely certain of their identity.
Explore related products
What You'll Learn
- Gill and Spore Color: Check for white gills and spores, a key death cap identifier
- Skirt-Like Ring: Look for a movable, skirt-like ring on the stem
- Volva at Base: Inspect for a cup-like volva (sheath) at the mushroom base
- Pale Green Cap: Note a pale green or yellowish cap, often with a bumpy texture
- Pleasant Odor: Beware of a pleasant, sweet, or honey-like smell, unusual for mushrooms

Gill and Spore Color: Check for white gills and spores, a key death cap identifier
When identifying a death cap mushroom, one of the most critical features to examine is the gill and spore color. Death caps, scientifically known as *Amanita phalloides*, typically have white gills that are closely spaced and free from the stem. These gills are located beneath the cap and are easily visible when the mushroom is mature. The white color is a key identifier, as it contrasts with the greenish-yellow or olive cap, making it a standout feature. Always ensure you inspect the gills carefully, as this characteristic is consistent across death caps and can help differentiate them from less harmful species.
In addition to the gills, the spore color is another crucial aspect to check. Death caps produce white spores, which are released from the gills as the mushroom matures. To verify spore color, you can perform a simple spore print test. Place the cap gill-side down on a dark surface (like a piece of paper or glass) and leave it undisturbed for several hours. The spores will drop and create a distinct white deposit. This white spore print is a definitive trait of death caps and should never be overlooked when identifying mushrooms in the wild.
It’s important to note that while white gills and spores are hallmark features of death caps, not all mushrooms with these traits are deadly. However, if you encounter a mushroom with a greenish or yellowish cap, a bulbous base, and white gills and spores, it is highly likely to be a death cap. Always err on the side of caution and avoid consuming any wild mushrooms unless you are absolutely certain of their identity. Misidentification can have fatal consequences, as death caps contain potent toxins that can cause severe organ damage or death.
When inspecting gills, look for their attachment to the stem. Death cap gills are typically free from the stem, meaning they do not extend down it. This, combined with their white color, makes them a reliable identifier. Additionally, the gills should appear smooth and even, without any jagged edges or discoloration. If you notice any irregularities, it may still be a death cap, but further examination of other features (like the cap, stem, and volva) is necessary for confirmation.
Lastly, remember that the white spore print is a diagnostic feature. While it requires a bit of time and patience to create, it is one of the most reliable methods for identifying death caps. If you’re unsure about a mushroom’s identity, always prioritize safety and consult a mycologist or field guide. The combination of white gills and spores, along with other death cap characteristics, should serve as a strong warning to avoid handling or ingesting the mushroom. Always treat mushroom foraging with respect and caution, especially when dealing with potentially lethal species like the death cap.
Fried Mushrooms: Vegan or Not?
You may want to see also

Skirt-Like Ring: Look for a movable, skirt-like ring on the stem
The presence of a skirt-like ring on the stem is a distinctive feature that can help you identify a Death Cap mushroom (*Amanita phalloides*). This ring, also known as a partial veil, is a remnant of the mushroom’s earlier development stage. As the cap expands, it breaks free from the partial veil, leaving behind a movable, skirt-like structure around the upper part of the stem. To spot this feature, carefully examine the stem of the mushroom. If you see a thin, membranous ring that can slide up and down the stem, it’s a strong indicator that you may be dealing with a Death Cap.
When inspecting the stem, note that the skirt-like ring is typically white or pale in color, blending in with the stem’s hue. Unlike other mushrooms where the ring may be more rigid or attached, the Death Cap’s ring is movable and delicate. Gently try to slide it up or down the stem—if it moves freely, this is a critical red flag. However, be cautious not to touch the mushroom with bare hands, as even contact with a Death Cap can be risky.
It’s important to distinguish this feature from similar structures in other mushrooms. For example, some edible mushrooms also have rings, but they are often more substantial or less movable. The Death Cap’s ring is thin and fragile, almost like a piece of tissue paper wrapped around the stem. If you’re unsure, compare it to images of Death Cap mushrooms to confirm the characteristic appearance of this ring.
To further validate your observation, consider the ring in conjunction with other Death Cap features. The skirt-like ring is usually found on a smooth, white to greenish stem with a bulbous base. If you notice the ring alongside these traits, the likelihood of it being a Death Cap increases significantly. Always remember that no single feature is definitive, so look for multiple identifying characteristics.
Finally, while the skirt-like ring is a helpful identifier, it’s not always present in every Death Cap. Environmental factors or the mushroom’s age can cause the ring to deteriorate or disappear. Therefore, if you suspect a mushroom might be a Death Cap but don’t see the ring, don’t assume it’s safe. Instead, focus on other key features like the volva (cup-like structure at the base), white gills, and pale green to yellowish cap. When in doubt, avoid handling or consuming any wild mushroom, especially if it resembles a Death Cap in any way.
Heartburn and Mushrooms: What's the Connection?
You may want to see also

Volva at Base: Inspect for a cup-like volva (sheath) at the mushroom base
When identifying a death cap mushroom (*Amanita phalloides*), one of the most critical features to inspect is the presence of a volva at the base. The volva is a cup-like structure that resembles a sheath or sac, and it is a key characteristic that distinguishes the death cap from many other mushrooms. To begin your inspection, carefully dig around the base of the mushroom to expose the entire stem and root-like structure. The volva is often buried in the soil or leaf litter, so gentle excavation is essential to avoid damaging it. Once exposed, look for a distinct, cup-shaped structure at the base of the stem. This volva is a remnant of the universal veil that once enclosed the entire mushroom during its early development.
The volva of a death cap mushroom typically appears as a white to off-white cup that may be partially or fully attached to the base of the stem. It is often delicate and can easily break apart, so handle the mushroom with care. Unlike other mushrooms that may have a bulbous base or faint remnants of a veil, the death cap’s volva is usually well-defined and clearly visible once uncovered. If you’re unsure, compare it to images of death cap volvas, which are widely available in field guides or online resources. Remember, the presence of a volva alone is not definitive proof of a death cap, but its absence rules it out entirely.
To ensure you don’t miss this crucial feature, always inspect the base thoroughly, even if the mushroom appears to be growing on the surface. The volva may be hidden beneath debris or partially submerged in the substrate. Use a small tool, like a knife or stick, to carefully brush away soil or leaves without disturbing the mushroom’s structure. If you find a cup-like volva, take note of its texture, color, and attachment to the stem. The volva of a death cap is often smoother and more distinct compared to other Amanita species, which may have a less defined or fragmented volva.
It’s important to note that not all death caps will have a perfectly intact volva, especially if the mushroom is mature or has been disturbed. However, even remnants of a volva should raise suspicion. If you’re foraging or simply observing mushrooms in the wild, always treat a mushroom with a volva at the base as potentially dangerous until you can confirm its identity. The death cap’s volva is a red flag that should never be ignored, as it is one of the most reliable indicators of this highly toxic species.
In summary, inspecting for a cup-like volva at the base is a critical step in identifying a death cap mushroom. Take the time to carefully excavate the base, look for a distinct, sheath-like structure, and compare it to known examples. While the volva is not the only feature to consider, its presence is a strong warning sign that the mushroom could be a death cap. Always prioritize safety and avoid consuming any mushroom with a volva unless you are absolutely certain of its identity.
Sniffer Dogs: Can They Detect Mushrooms?
You may want to see also
Explore related products

Pale Green Cap: Note a pale green or yellowish cap, often with a bumpy texture
When identifying a death cap mushroom, one of the key features to look for is the pale green cap, which can also appear yellowish in certain lighting conditions. This coloration is a significant red flag, as it distinguishes the death cap (*Amanita phalloides*) from many other mushrooms. The shade of green can vary, ranging from a faint, almost lime hue to a more muted olive tone. It’s important to observe the cap closely, as this characteristic alone can be a critical warning sign. If you notice a mushroom with a cap in this color range, proceed with caution and examine other features to confirm its identity.
The texture of the pale green cap is another important detail to note. Death caps often have a bumpy or slightly granular texture, which can be more pronounced in mature specimens. These bumps are not always obvious at first glance, so running your finger gently over the cap can help you detect this feature. The bumps may appear as small, raised areas or a subtle roughness across the surface. This texture, combined with the pale green or yellowish color, is a strong indicator that you may be dealing with a death cap mushroom.
It’s worth mentioning that the pale green cap may also have a slightly sticky or viscid feel, especially in humid conditions. This is due to a thin layer of gelatinous material on the cap’s surface, which can make it appear shiny or glossy. However, this stickiness can be less noticeable in drier environments, so don’t rely solely on this trait. Instead, focus on the color and texture as primary identifiers. If the cap matches the pale green or yellowish description and feels bumpy, it’s a clear signal to investigate further.
When examining the pale green cap, also pay attention to its shape and size. Death caps typically have a convex cap that flattens with age, often reaching diameters of 5 to 15 centimeters. The edges of the cap may be slightly striated or lined, especially when young, which can be seen when viewed from the side. This combination of color, texture, and shape is unique to the death cap and sets it apart from edible or less toxic species. Always remember that while the pale green cap is a key feature, it should be confirmed with other characteristics like the presence of a cup-like volva at the base and a skirt-like ring on the stem.
Lastly, it’s crucial to emphasize that the pale green or yellowish cap with a bumpy texture is not a feature to ignore. Misidentification of the death cap can have severe, even fatal, consequences. If you encounter a mushroom with these traits, do not handle it without gloves, and avoid consuming it under any circumstances. Instead, document your findings with photographs and consult a mycologist or field guide for confirmation. Being vigilant about the pale green cap and its associated features can help prevent accidental poisoning and ensure safe foraging practices.
Meat Tacos: Adding Mushrooms for a Delicious Twist
You may want to see also

Pleasant Odor: Beware of a pleasant, sweet, or honey-like smell, unusual for mushrooms
When foraging for mushrooms, one of the most deceptive traits of the death cap mushroom (*Amanita phalloides*) is its pleasant odor. Unlike many mushrooms that have earthy, musky, or neutral scents, the death cap often emits a sweet, honey-like, or pleasant aroma. This unusual fragrance can be particularly misleading, as it may attract unsuspecting foragers who associate such a smell with edibility. However, this sweet scent is a red flag and should immediately raise suspicion. Always remember that a pleasant odor in a wild mushroom, especially one as potent as the death cap, is highly uncommon and warrants extreme caution.
The sweet or honey-like smell of the death cap is a result of its chemical composition, which includes toxins like amatoxins. These toxins are odorless, but the mushroom’s overall fragrance can be misleadingly appealing. Foragers, especially beginners, may be tempted to trust their sense of smell as a quick indicator of safety, but this is a dangerous mistake. The death cap’s pleasant odor is one of its most insidious features, as it can easily trick even experienced mushroom hunters into underestimating its lethality. Always prioritize visual identification and other characteristics over scent when assessing wild mushrooms.
To avoid confusion, it’s crucial to understand that most edible mushrooms have mild, earthy, or nutty aromas, not sweet or honey-like ones. If you encounter a mushroom with a pleasant odor, particularly in the Amanita genus, assume it is toxic until proven otherwise. The death cap’s sweet smell is often described as cloying or overly fragrant, which can feel out of place in a forest environment. Trust your instincts—if a mushroom’s scent seems too good to be true, it probably is. Never consume a wild mushroom based solely on its odor, especially if it matches the death cap’s distinctive fragrance.
When inspecting mushrooms, always combine odor assessment with other identification methods. Look for the death cap’s characteristic features, such as its pale green or yellowish cap, white gills, and volva (a cup-like structure at the base). If you detect a pleasant, sweet, or honey-like smell alongside these traits, you are likely dealing with a death cap. In such cases, do not touch the mushroom without gloves, and avoid collecting it for further examination. The combination of its alluring scent and deadly toxicity makes the death cap a prime example of why odor alone is an unreliable indicator of safety in mushroom foraging.
Finally, educate yourself and others about the dangers of relying on pleasant odors in mushroom identification. The death cap’s sweet smell is a classic example of nature’s deception, luring foragers into a false sense of security. Always carry a reliable field guide, consult experts, and when in doubt, throw it out. The risk of mistaking a death cap for an edible mushroom due to its pleasant odor is simply not worth the potential consequences. Stay vigilant, and let the death cap’s sweet scent serve as a warning rather than an invitation.
The Magic of Rehydrating Mushrooms: A Quick Guide
You may want to see also
Frequently asked questions
Death Cap mushrooms (Amanita phalloides) typically have a pale green to yellowish-green cap, often with a smoother texture, a bulbous base with a cup-like volva, and white gills. The cap can range from 5 to 15 cm in diameter, and the stem is usually 8 to 15 cm tall with a ring (partial veil remnants).
Death Caps are often found in wooded areas, particularly under oak, beech, and pine trees, in Europe, North America, and Australia. They typically fruit in late summer to fall, coinciding with cooler, wetter weather.
Death Caps can resemble edible mushrooms like the Paddy Straw mushroom or young Agaricus species. Key differences include the Death Cap's greenish cap, bulbous base with a volva, and persistent ring on the stem. Always consult a reliable field guide or expert if unsure, as misidentification can be fatal.